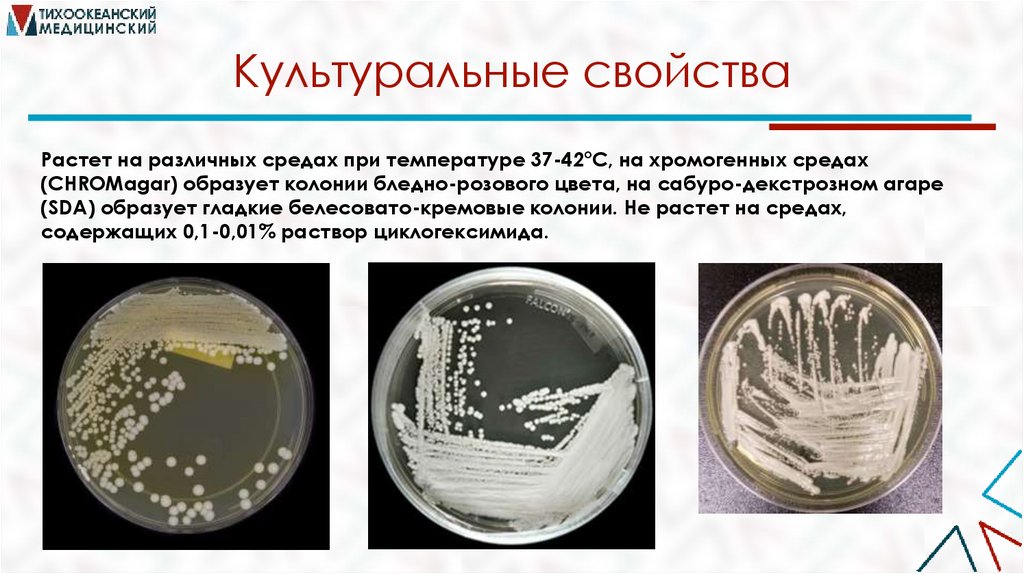
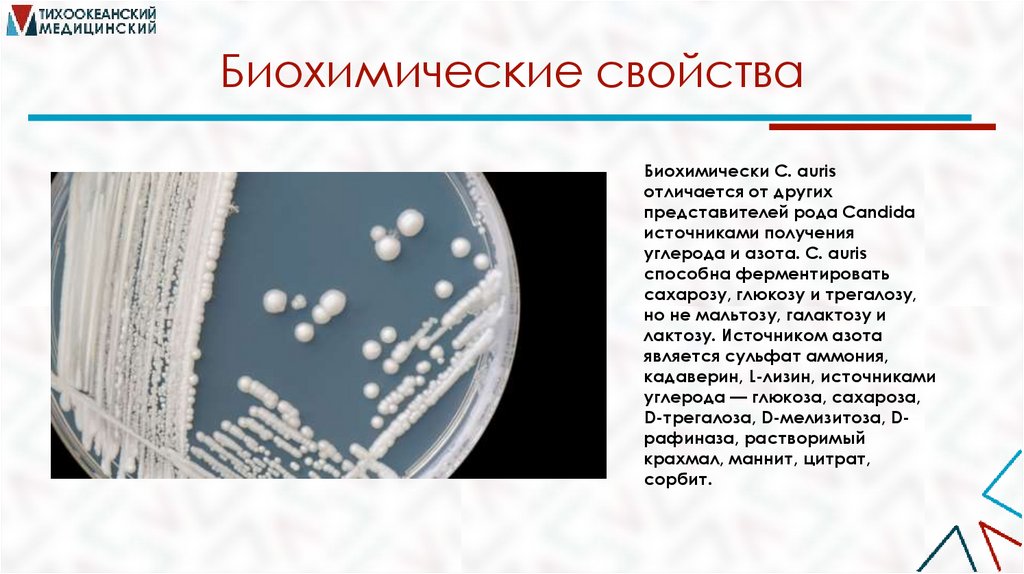

Similar presentations:
Candida auris (Кандида аурис)
1.
Candida auris (Кандидааурис)
Никора Е.Р., Алексеева Е.А., 203 группа,
педиатрический факультет.
2.
Candida aurisВид грибка, который растет как дрожжи. Это один из немногих
видов рода Candida, вызывающих кандидоз у человека.
3.
Микробиологическая характеристикаC. auris принадлежит к семейству
Metschnikowiaceae и филогенетически
схожа с C. haemulonii и C. pseudohaemulonii. Представляет собой клетки
овальной или эллиптической формы
размерами 2,0-3,0х 2,5-5,0 мкм, которые
располагаются одиночно или парами.
Этот микроорганизм, в отличие от других
представителей рода Candida, не
образует гифов и хламидоспор, однако
склонен к образованию псевдогифов,
что также является отличительной
характеристикой этого гриба.
4.
Культуральные свойстваРастет на различных средах при температуре 37-42°С, на хромогенных средах
(CHROMagar) образует колонии бледно-розового цвета, на сабуро-декстрозном агаре
(SDA) образует гладкие белесовато-кремовые колонии. Не растет на средах,
содержащих 0,1-0,01% раствор циклогексимида.
5.
Биохимические свойстваБиохимически C. auris
отличается от других
представителей рода Candida
источниками получения
углерода и азота. C. auris
способна ферментировать
сахарозу, глюкозу и трегалозу,
но не мальтозу, галактозу и
лактозу. Источником азота
является сульфат аммония,
кадаверин, L-лизин, источниками
углерода — глюкоза, сахароза,
D-трегалоза, D-мелизитоза, Dрафиназа, растворимый
крахмал, маннит, цитрат,
сорбит.
6.
Какие заболевания возможны?Кандида аурис провоцирует целую группу заболеваний:
Бронхит.
Воспаление легких или пневмония.
Поражения ротоглотки разной степени тяжести.
Поражения суставов.
Гломерулонефрит, тяжелый пиелонефрит.
Патологии органов слуха.
Заболевания инфекционного типа, поражающие головной мозг.
Прочие поражения органов мочеотделительного тракта. Также
пищеварительной системы.
Сепсис.
7.
Клиническая картинаКлиническая картина нетипичная для поражения именно этим
грибком. Среди признаков:
Тахикардия.
Нестабильность артериального давления.
Олигурия.
Увеличение частоты дыхательных движений.
Слабость, сонливость.
Невозможность двигаться из-за ощущения «ватности» тела
Нарушения сознания.
Рост печеночных проб. АЛТ, АСТ, билирубина.
Нарушения работы поджелудочной железы.
8.
Пути передачиТрансмиссивный
путь
Моча, также
Специфические
секреты органов
репродуктивной
системы.
Физический
или контактный
путь
Мокрота,
частички слизи

biology
biology








